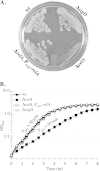
FIG 1

RelA inhibits Bacillus subtilis motility and chaining
- PMID: 25331430
- PMCID: PMC4288673
- DOI: 10.1128/JB.02063-14
RelA inhibits Bacillus subtilis motility and chaining
Abstract
The nucleotide second messengers pppGpp and ppGpp [(p)ppGpp] are responsible for the global downregulation of transcription, translation, DNA replication, and growth rate that occurs during the stringent response. More recent studies suggest that (p)ppGpp is also an important effector in many nonstringent processes, including virulence, persister cell formation, and biofilm production. In Bacillus subtilis, (p)ppGpp production is primarily determined by the net activity of RelA, a bifunctional (p)ppGpp synthetase/hydrolase, and two monofunctional (p)ppGpp synthetases, YwaC and YjbM. We observe that in B. subtilis, a relA mutant grows exclusively as unchained, motile cells, phenotypes regulated by the alternative sigma factor SigD. Our data indicate that the relA mutant is trapped in a SigD "on" state during exponential growth, implicating RelA and (p)ppGpp levels in the regulation of cell chaining and motility in B. subtilis. Our results also suggest that minor variations in basal (p)ppGpp levels can significantly skew developmental decision-making outcomes.
Copyright © 2015, American Society for Microbiology. All Rights Reserved.
Figures

References
-
- Cozy LM, Phillips AM, Calvo RA, Bate AR, Hsueh YH, Bonneau R, Eichenberger P, Kearns DB. 2012. SlrA/SinR/SlrR inhibits motility gene expression upstream of a hypersensitive and hysteretic switch at the level of sigma(D) in Bacillus subtilis. Mol Microbiol 83:1210–1228. doi:10.1111/j.1365-2958.2012.08003.x. - DOI - PMC - PubMed
Publication types
MeSH terms
Substances
LinkOut - more resources
Full Text Sources
Other Literature Sources
Molecular Biology Databases

